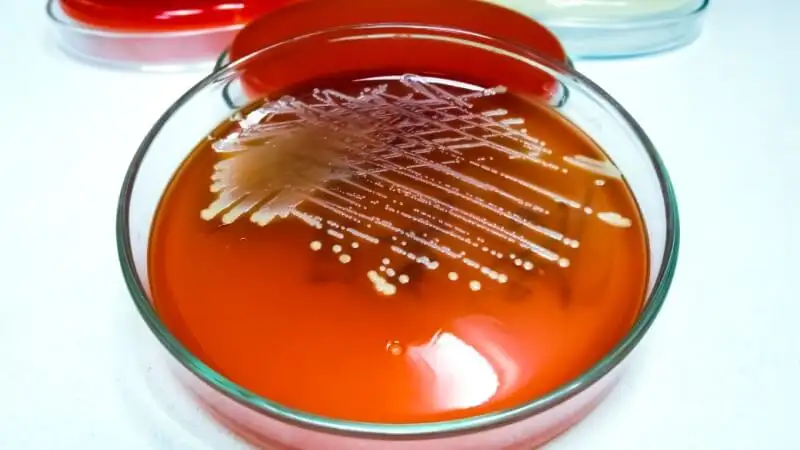

Jakie są skutki zarażenia gronkowcami (Staphylococcus)?
03.01.2020
O bakteriach Staphylococcus
Rodzaj Staphylococcus jest powszechnie znany pod nazwą gronkowiec, a jego najczęściej spotykanym przedstawicielem jest S. aureus czyli gronkowiec złocisty. Bakterie te są Gram-dodatnie i mogą rozwijać się zarówno w warunkach tlenowych jak i beztlenowych.
Bakterie tego rodzaju zamieszkują głównie skórę i błony śluzowe ssaków i ptaków. Spośród 32 poznanych gatunków Staphylococcus znanych jest 16, które kolonizują organizmy człowieka, to: S. aureus, S. auricularis, S. capitis, S. caprae, S. cohnii, S. epidermidis, S. haemolyticus, S. leei, S. lugdunensis, S. pasteuri, S. pettenkoferi, S. schleiferi, S. sciuri, S. simulans, S. warneri, S. xylosus. Gronkowiec złocisty u człowieka lokalizuje się najczęściej w nosie i gardle, na skórze głowy graniczącej z włosami oraz w okolicach odbytu.
Czy w moich jelitach żyją bakterie Staphylococcus?
Ze względu na chorobotwórczość bakterii z rodzaju Staphylococcus istotne jest zbadanie, czy ich liczebność w jelitach może stanowić dla nas zagrożenie. Dzięki łatwo następującym badaniom mikroflory jelitowej jest to możliwe:
- GutFlora ❱
- MikroFloraScan ❱
- KyberKompakt ❱
Polegają one na analizie próbki kału w kierunku zamieszkujących jelita bakterii i grzybów, które mogą mieć pozytywne działanie bądź w niektórych warunkach stawać się chorobotwórcze. Do pierwszej grupy należą przede wszystkim bakterie z rodzaju Bifidobacterium i Lactobacillus. Wśród potencjalnie chorobotwórczych znajdują się takie bakterie jak Pseudomonas, Klebsiella, Enterococcus, Clostridium, Proteus, E. coli czy drożdżaki z rodzaju Candida. Dodatkowo niektóre z badań mają w swoim zakresie analizę dodatkowych markerów stanu zapalnego, wśród których są: krew utajona w kale, kalprotektyna, zonulina.
Chorobotwórczość Staphylococcus
Do zakażeń gronkowcami najczęściej dochodzi w szpitalach poprzez kontakt dłońmi bądź drogę kropelkową. Największe ryzyko infekcji wiąże się z zabiegami chirurgicznymi, obecnością cewników naczyniowych, wszczepionych protez (mają zdolność do adhezji), z ranami po poparzeniach oraz stosowania przewlekłej antybiotykoterapii. Do grupy ryzyka należą również osoby w stanie immunosupresji, np. w trakcie leczenia onkologicznego czy zakażonych HIV.
Gronkowca złocistego uznaje się za jednego z groźniejszych patogenów u człowieka. Jest on oporny na większość leków przeciwbakteryjnych. Wśród czynników pozwalających na skuteczną kolonizację S. aureus w organizmie człowieka jest obecność otoczki polisacharydowej, tworzenie biofilmu, zdolność do wytwarzania toksyn i enzymów, które uszkadzają tkanki.
Konsekwencje zakażenia gronkowcami
- Zapalenie płuc
- Zapalenia kości i szpiku
- Zapalenie wsierdzia, żył
- Stany zapalne skóry
- Zapalenie opon mózgowo-rdzeniowych
- Zapalenie spojówek
- Zapalenie ucha środkowego i zatok
- Gronkowcowe zapalenie płuc
- Zapalenia układu kostnego
- Zatrucia pokarmowe
- Wstrząs toksyczny
- Sepsa

Infekcje skórne a gronkowiec złocisty
Gronkowiec złocisty jest w znacznej mierze odpowiedzialny za problemy dermatologiczne takie jak czyraki, czyraczność, liszajec, ropnie, zapalenia mieszków włosowych, gruczołów potowych czy gruczołu piersiowego. W rzadszych przypadkach zakażenie obejmuje również tkanki podskórne czy powięzie, w których przypadkach konieczne jest już zastosowanie zabiegów chirurgicznych, gdyż zapalenie powięzi ma przebieg gwałtowny związany z wytworzoną przez Staphylococcus toksyną.
Zakażenia układu krążenia
Najcięższe powikłania wiążą się z rozprzestrzenieniem się Staphylococcus wraz z krwią. Posocznica prowadzi bezpośrednio do zapaleń wsierdzia, zastawek sercowych (naturalnych i sztucznych) czy cewników naczyniowych. Takie zakażenia mają wysoką śmiertelność.Wtórnie dochodzi również do zakażeń płuc, nerek, układu nerwowego czy układu kostnego.
Rzadkim, ale najcięższym powikłaniem jest gronkowcowe zapalenie płuc. Występuje najczęściej u chorych w szpitalach podłączonych do respiratora oraz w okresie grypowym.
Zapalenia układu kostnego
Zapalenie kości lub stawów również może zostać spowodowane gronkowcem złocistym. Niemowląt problem ten nie dotyczy, w przypadku dzieci zakażenie najczęściej obejmuje kości długie, zaś u dorosłych kości kręgosłupa. Innym częstym problemem są zakażenia torebek stawowych i protez.
Zatrucia pokarmowe
Enterotoksyny wytwarzane przez Staphylococcus aureus mogą powodować zatrucia po spożyciu pokarmów, w których gronkowce się namnożyły. Zazwyczaj mdłości i wymioty rozpoczynają się w 2-6 godzin od spożycia, a później pojawia się ból brzucha i biegunka.
Gronkowce lubią warunki z wysokimi stężeniami białka, cukru bądź soli, dlatego do zatruć dochodzi po zjedzeniu mięsa, produktów mlecznych czy lodów. Główną przyczyną jednak jest niewłaściwe przechowywanie produktów.
Gronkowcowy wstrząs toksyczny
Jedna z toksyn gronkowca prowadzi do zagrażającego życiu wstrząsu toksycznego. Objawia się to spadkiem ciśnienia tętniczego, wysoką gorączką, obecnością rozlanych zmian na skórze i upośledzeniem czynności narządów, wymiotami, biegunką i bólami mięśni. Wstrząs toksyczny najczęściej wiązany jest z kobietami stosującymi tampony, jednak problem ten występuje jednak u obu płci i w każdej grupie wiekowej.
Zapobieganie zakażeniom Staphylococcus
Szeroko zakrojona polityka zmierzająca do zmniejszenia ilości występujących zakażeń szpitalnych, w głównej mierze dotyczy zapobiegania zakażeniom gronkowcowym. Podstawowym sposobem uniknięcia przeniesienia zakażenia jest stosowanie standardowej izolacji kontaktowej.
Bibliografia:
- Rogalska M.: Zakażenia gronkowcowe. Medycyna Praktyczna.
- Foster T. Staphylococcus. In: Baron S, editor. Medical Microbiology. 4th edition. Galveston (TX): University of Texas Medical Branch at Galveston; 1996. Chapter 12.
Autor merytoryczny: Mgr Katarzyna Startek, Dietetyk

